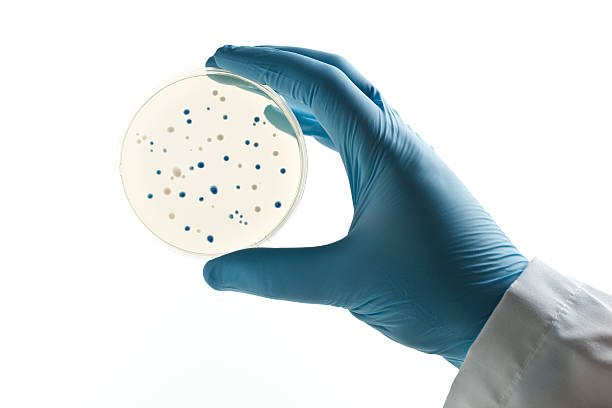

Dip
A downloadable COMPUTER GAME for Windows
Get this COMPUTER GAME and 5 more for $10.50 USD
Pre-order Now$1.50 USD or more
from SPRITE KID

♫ "Tangy! - Chemical Remix"
pixeled with SmileBASIC 
"text goes here
"
WELCOME TO THE UNSEEN, SEEN
THE BEGINNING AND END OF ALL THINGS
THE DIP 
| Updated | 22 days ago |
| Status | Released |
| Platforms | Windows |
| Author | Funky Tiger Highsaturn |
| Tags | Point & Click |
| Average session | About a half-hour |
| Inputs | Keyboard, Mouse |
Purchase
Get this COMPUTER GAME and 5 more for $10.50 USD
Pre-order Now$1.50 USD or more
In order to download this COMPUTER GAME you must purchase it at or above the minimum price of $1.50 USD. You will get access to the following files when they are released:
AUTOJUNKIO NEW PLAYER TOKEN
Download demo
Download
Dip [DEMO] 9.1 MB


